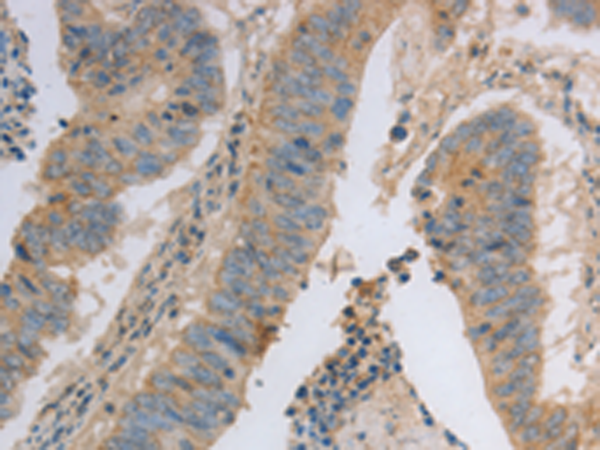
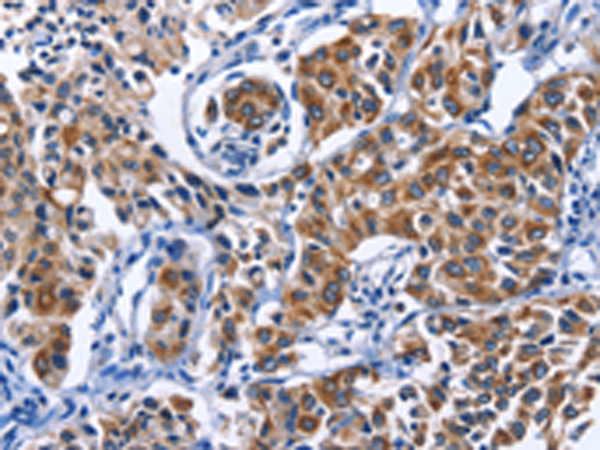
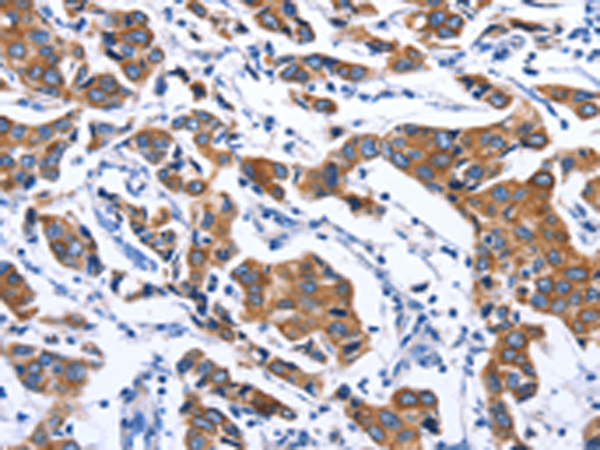

-
分类: 科研抗体货号: P07473别名: EBN; BFNC; EBN1; NACHR; NACRA4; NACHRA4应用: WB,IHC反应种属: Human
-
分类: 科研抗体货号: P07452别名: ME; HME; MME; MMP-12应用: WB,IHC反应种属: Human
-
分类: 科研抗体货号: P07433别名: NRAGE, DLXIN-1应用: WB,IHC反应种属: Human, Mouse, Rat
-
分类: 科研抗体货号: P07472别名: LC17; ESMLC; LC17A; LC17B; MLC-3; MLC1SM; MLC3NM; MLC3SM; LC17-GI; LC17-NM应用: WB,IHC反应种属: Human, Mouse, Rat
-
分类: 科研抗体货号: P07451别名: KMLC; MLCK; MLCK2; skMLCK应用: IHC反应种属: Human, Mouse, Rat
-
分类: 科研抗体货号: P07432别名: GMA; S-MAG; SIGLEC4A; SIGLEC-4A应用: WB,IHC反应种属: Human, Mouse, Rat
-
分类: 科研抗体货号: P07471别名: MYHa; MYHSA1; MyHC-2x; MyHC-2X/D应用: IHC反应种属: Human, Mouse
-
分类: 科研抗体货号: P07450别名: MIC-A; PERB11.1应用: WB,IHC反应种属: Human
-
分类: 科研抗体货号: P07464别名:应用: IHC反应种属: Human
-
分类: 科研抗体货号: P07470别名: CMH1; MPD1; SPMD; SPMM; CMD1S; MYHCB应用: IHC反应种属: Human, Mouse, Rat

鄂公网安备42018502007531号
鄂公网安备42018502007531号

